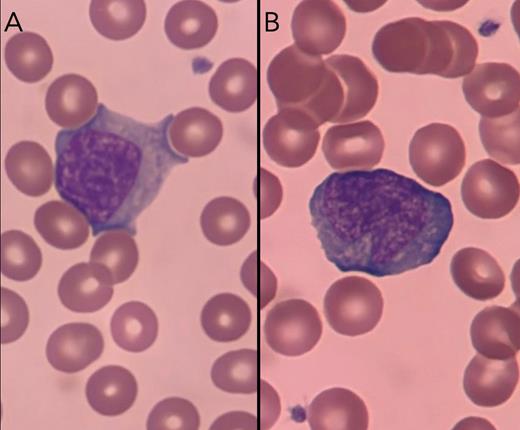
Peripheral blood smear

A 30-year-old male presented with two weeks of fevers, night sweats, and fatigue, as well as splenomegaly and cervical lymphadenopathy. Laboratory studies showed a lymphocyte count of 6.2 x 103/μl (reference value, 1.2 to 5). A peripheral blood smear is shown in Figure 1. The patient subsequently developed acute and severe abdominal pain in the right hypochondrium. A splenic rupture was detected on computed tomography (Figure 2).
Peripheral blood smear
Large cells with abundant pale blue cytoplasm are shown in the center of panels A and B. Compared to a normal lymphocyte, the chromatin is less crumpled and the cytoplasm surrounds the adjacent red blood cells (RBCs). Marked basophilia is observed at the points where the cells come into contact with the RBCs.
Peripheral blood smear
Large cells with abundant pale blue cytoplasm are shown in the center of panels A and B. Compared to a normal lymphocyte, the chromatin is less crumpled and the cytoplasm surrounds the adjacent red blood cells (RBCs). Marked basophilia is observed at the points where the cells come into contact with the RBCs.
Computed tomography of splenic rupture
Yellow arrow indicates rupture site. Yellow asterisk marks subcapsular hematoma.
Computed tomography of splenic rupture
Yellow arrow indicates rupture site. Yellow asterisk marks subcapsular hematoma.
What is the diagnosis?
Acute lymphoblastic leukemia
Infectious mononucleosis (Test for Epstein-Barr virus and cytomegalovirus.)
Acute retroviral infection (Test for human immunodeficiency virus.)
Aggressive lymphoma
For the solution to the quiz, visit The Hematologist online at hematology.org/TheHematologist/Image-Challenge.
Disclosure Statement
The authors indicated no relevant conflicts of interest.